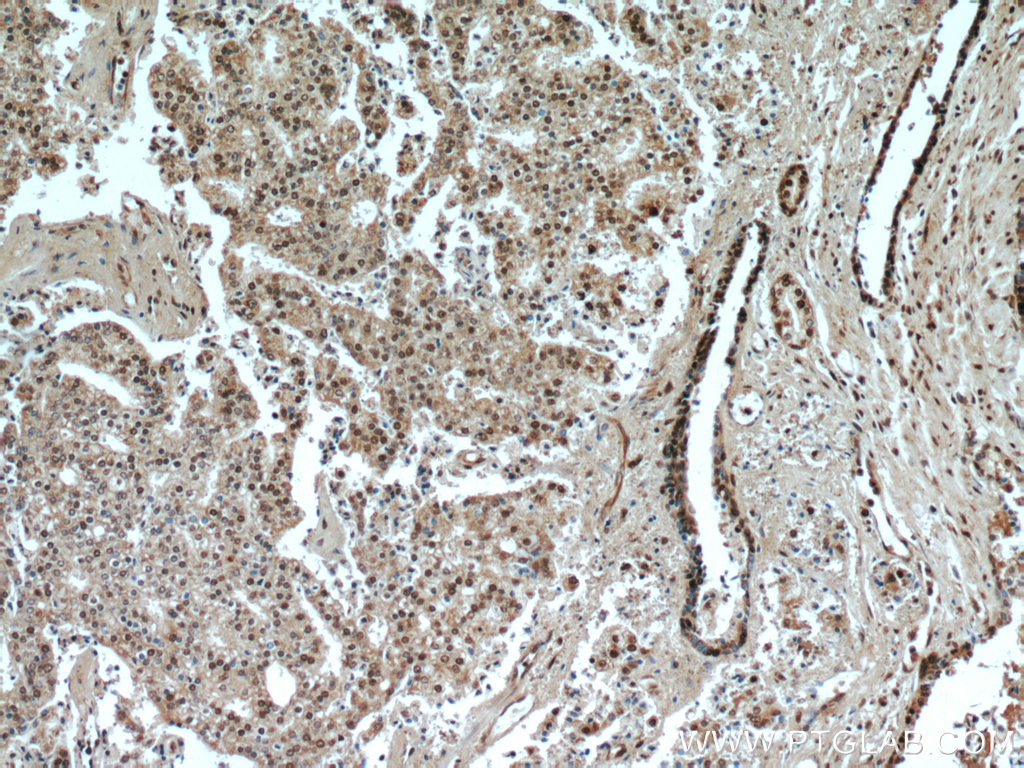
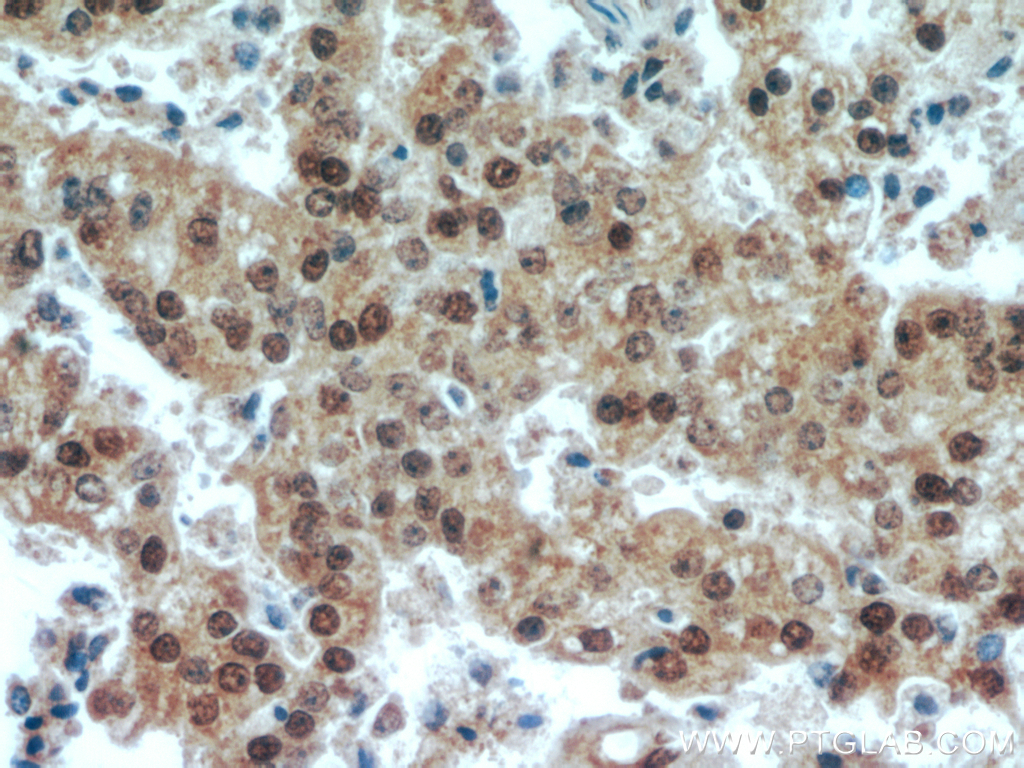

验证数据展示
经过测试的应用
| Positive WB detected in | HEK-293T cells, mouse brain tissue, HeLa cells, Jurkat cells, K-562 cells |
| Positive IHC detected in | human prostate cancer tissue, human brain tissue Note: suggested antigen retrieval with TE buffer pH 9.0; (*) Alternatively, antigen retrieval may be performed with citrate buffer pH 6.0 |
推荐稀释比
| 应用 | 推荐稀释比 |
|---|---|
| Western Blot (WB) | WB : 1:1000-1:6000 |
| Immunohistochemistry (IHC) | IHC : 1:300-1:1200 |
| It is recommended that this reagent should be titrated in each testing system to obtain optimal results. | |
| Sample-dependent, Check data in validation data gallery. | |
发表文章中的应用
| WB | See 2 publications below |
产品信息
20260-1-AP targets TAF1-Specific in WB, IHC, ELISA applications and shows reactivity with human, mouse samples.
| 经测试应用 | WB, IHC, ELISA Application Description |
| 文献引用应用 | WB |
| 经测试反应性 | human, mouse |
| 文献引用反应性 | human |
| 免疫原 |
Peptide 种属同源性预测 |
| 宿主/亚型 | Rabbit / IgG |
| 抗体类别 | Polyclonal |
| 产品类型 | Antibody |
| 全称 | TAF1 RNA polymerase II, TATA box binding protein (TBP)-associated factor, 250kDa |
| 别名 | BA2R, CCG1, CCGS, Cell cycle gene 1 protein, DYT3, KAT4, N TAF1, NSCL2, OF, P250, TAF(II)250, TAF1, TAF1-Specific, TAF2A, TAFII 250, TAFII250, TBP associated factor 250 kDa |
| 计算分子量 | 213 kDa |
| 观测分子量 | 250-260 kDa, 50 kDa |
| GenBank蛋白编号 | NM_138923 |
| 基因名称 | TAF1 |
| Gene ID (NCBI) | 6872 |
| RRID | AB_10693532 |
| 偶联类型 | Unconjugated |
| 形式 | Liquid |
| 纯化方式 | Antigen affinity purification |
| UNIPROT ID | P21675 |
| 储存缓冲液 | PBS with 0.02% sodium azide and 50% glycerol, pH 7.3. |
| 储存条件 | Store at -20°C. Stable for one year after shipment. Aliquoting is unnecessary for -20oC storage. |
背景介绍
TAF1, also named as BA2R, CCG1, CCGS, TAF2A, p250, Cell cycle gene 1 protein, TAFII250 and DYT3, belongs to the TAF1 family. TAF1 is the largest component and core scaffold of the TFIID basal transcription factor complex. It contains novel N- and C-terminal Ser/Thr kinase domains which can autophosphorylate or transphosphorylate other transcription factors. TAF1 phosphorylates TP53 on 'Thr-55' which leads to MDM2-mediated degradation of TP53. TAF1 phosphorylates GTF2A1 and GTF2F1 on Ser residues. It possesses DNA-binding activity. It is essential for progression of the G1 phase of the cell cycle. Defects in TAF1 are the cause of dystonia type 3 (DYT3) which also called X-linked dystonia-parkinsonism (XDP). The antibody is specific to TAF1. It has several isoforms with predicted MW's of 200-250 kDa and 170-180 kDa, it also could get about 50 kDa band which is caused by the lysate preparation.
实验方案
| Product Specific Protocols | |
|---|---|
| IHC protocol for TAF1-Specific antibody 20260-1-AP | Download protocol |
| WB protocol for TAF1-Specific antibody 20260-1-AP | Download protocol |
| Standard Protocols | |
|---|---|
| Click here to view our Standard Protocols |
发表文章
| Species | Application | Title |
|---|---|---|
J Extracell Vesicles Extracellular vesicle-mediated delivery of circDYM alleviates CUS-induced depressive-like behaviours. | ||
J Clin Invest Long noncoding RNA HITT coordinates with RGS2 to inhibit PD-L1 translation in T cell immunity | ||
J Transl Med Synergistic effect of mesenchymal stem cell-derived extracellular vesicle and miR-137 alleviates autism-like behaviors by modulating the NF-κB pathway |